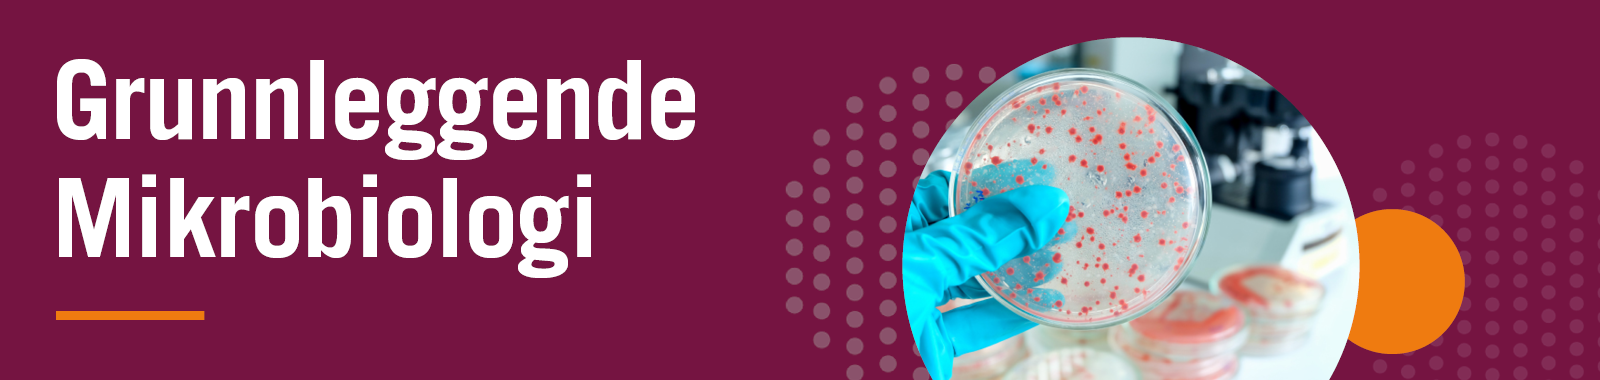
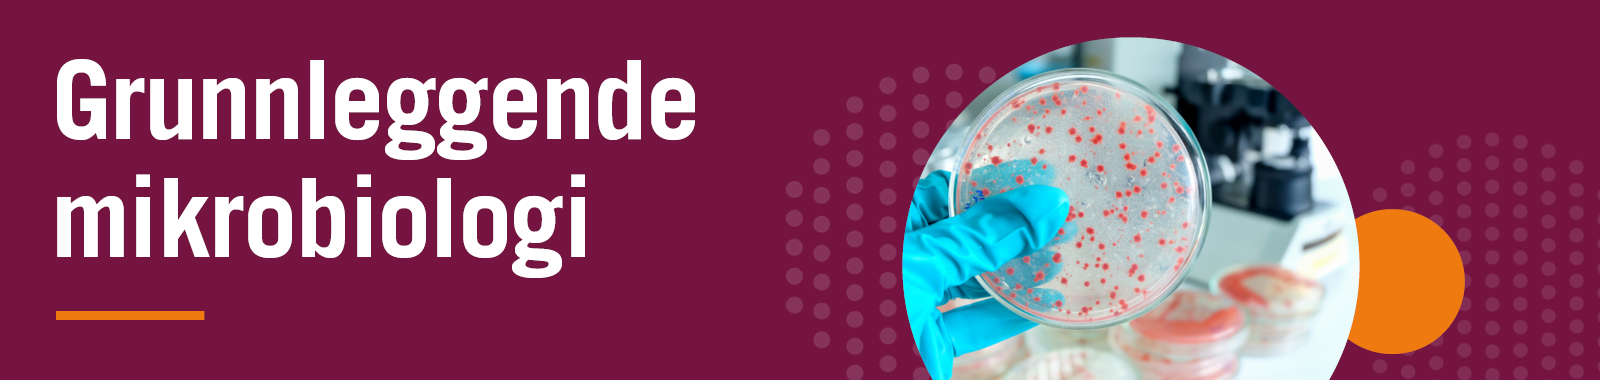

Grunnleggende mikrobiologi
Forstå mikroorganismenes rolle i mattrygghet
Mikroorganismer finnes overalt – også i mat. Noen er nyttige, andre kan forårsake sykdom eller ødelegge produkter. For å sikre trygg mat, er det viktig å forstå hvilke mikroorganismer som finnes, hvordan de oppfører seg og hvilke tiltak som hindrer vekst og spredning. Dette e-læringskurset gir en grunnleggende innføring i mikrobiologi med fokus på matproduksjon. Du lærer hva bakterier, virus, mugg og gjær egentlig er, hva som påvirker vekstforholdene deres – og hvordan produksjonsmiljø, temperatur og hygiene spiller en avgjørende rolle i forebygging av mikrobiell risiko.
Hva lærer du i kurset?
Hva er mikroorganismer? En innføring om bakterier, virus, mugg og gjær – og hvordan de kan påvirke maten
Nyttige vs. skadelige bakterier: Forstå forskjellen på ønskede og uønskede mikroorganismer i produksjonen
Vekstbetingelser: Lær hvilke faktorer som påvirker mikrobiell vekst, som temperatur, vannaktivitet og pH
Kontroll og forebygging: Hvordan hygienetiltak, kjøling, varmebehandling og gode rutiner reduserer risikoen
Mikrobiologi i praksis: Lær hvordan mikrobiologisk forståelse inngår i risikovurdering og i arbeidet for trygg mat
Læringsmål
Deltageren får en grunnleggende forståelse av mikroorganismer og deres betydning for mattrygghet. Kurset gir kunnskap om ulike typer mikroorganismer, smittekilder og vekstforhold – samt hvordan god hygiene og riktige prosessrutiner hindrer uønsket mikrobiell vekst og spredning i matproduksjon.
Målgruppe
Kurset passer for alle som jobber med produksjon, kvalitetsarbeid eller kontroll i næringsmiddelbransjen, og som trenger en grunnleggende forståelse av mikrobiologiske farer.
Kurset krever ingen forkunnskaper.
Informasjon
Pris: Kr. 650,- per deltager (eks mva)
Varighet: Ca. 30 minutter
Språk: Norsk
Tilgang: 6 måneder fra påloggingsdato
Kursdeltageren kan ta pause når som
helst i kurset og fullføre på et senere tidspunkt
Spørsmål?
Sjekk ut vår FAQ med ofte stilte spørsmål og svar om e-læring.
FAQ →Food Consulting
Mattrygghetskonsulenter
Tel: 480 66 771
foodconsulting@ftn.eurofins.com
Innhold
Modul 1 – Generell mikrobiologi
Modul 2 – Vekstforhold
Modul 3 – Sporedannende bakterier
Modul 4 – Matbåren sykdom
Eksamen
Dokumentert opplæring
Ved bestått e-læringskurs, vil deltageren kunne laste ned kursbevis som kan benyttes som dokumentasjon for bedriftens internkontroll.
Inkludert i kurspakke
Dette kurset er også tilgjengelig i kurspakken, Farer i matproduksjon.
Kurspakke →
Flere ansatte?
Ønsker du kurspakker for flere ansatte? Vi tilbyr bedriftsløsninger og rabatter ved større volum – kontakt oss for mer informasjon.
Sjekk ut våre kursprogram
To kurspakker – én for deg som vil lære det grunnleggende, én for deg som vil dykke dypere: